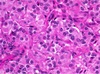

Figure illustrates 4 histological variations of Thyroid follicele appearance , define each one






Thyroid tissue


Thyroid tissue ;
Define the symbol and identify the stain used


Thyroid tissue ;
Define the symbol and identify the stain used








what” the thyroid pathology ?


Thyroid microscopy ; describe an diagnose


Multinodular thyroid goiter Gross picture ; describde

Cross-section of a thyroid gland with multinodular goiter. Secondary changes such as hemorrhage and cystic degeneration can be seen. Some of the nodules (»_space; ) are surrounded by an intact capsule.
Pathological Thyroid microscopy ; define the abnormalities and diagnose


Pathological Thyroid microscopy ; define the abnormalities and diagnose


Multinodular goiter Clinical presentation ?
• Markedly enlarged goiter
• Compression on trachea, esophagus (leading to dysphasia, stridor)
• Hyperfunction of thyroid gland (toxic multinodular goiter) with suppressed TSH +/- elevated free T4 or T3




histological picture of Embryonal adenoma ?
closely packed cells forming cords or trabeculae
histological picture of Fetal adenoma ?
small follicles containing no or little colloid separated by abundant loose connective tissue
histological picture of Simple adenoma ?
shows closely packed follicles of normal size
histological picture of Colloid adenoma ?
large follicles filled with colloid and lined by flat epithelium
histological picture of Hürthle cell adenoma ?
shows large granular cells with abundant eosinophilic cytoplasm arranged in trabecular pattern